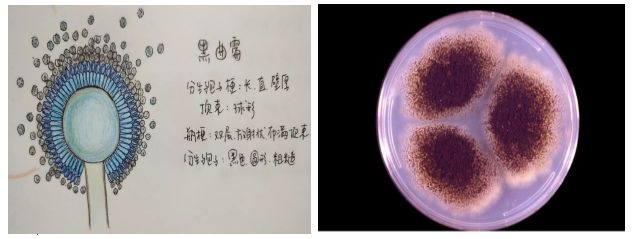
�DƬ
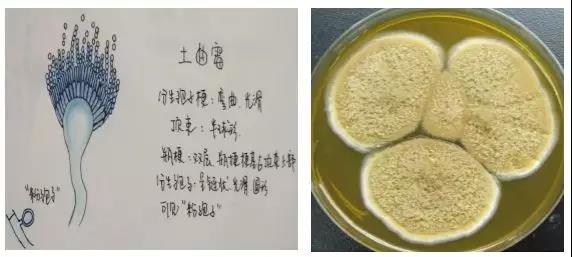
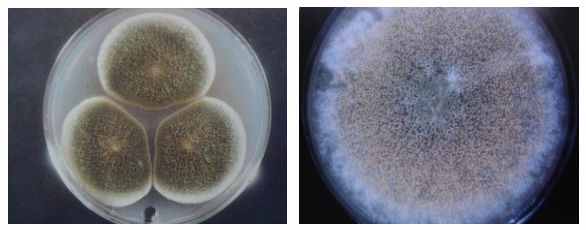

一、霉菌
不是分類學(xué)上的名詞,而是一些絲狀真菌的通稱,屬真菌的一部分;其對人類具有雙重性,有利的方面是它可以用來釀造、工業(yè)發(fā)酵、抗生素和酶制劑的生產(chǎn)等,不利方面是它能引起農(nóng)副產(chǎn)品、食品、原料及器材的腐爛,也感染并引起人類和動、植物的多種疾病,少數(shù)種類,如黃曲霉,能產(chǎn)生黃曲霉毒素,黃曲霉毒素是一種致癌物質(zhì),危害人、畜的健康和生命。因此,霉菌的檢測對于食品的安全性很重要。
二、食品種常見的霉菌
1、曲霉菌屬
曲霉菌是一種典型的絲狀菌,占空氣中真菌的12%左右,它以土壤或空氣為媒介, 可引起食物、谷物、豆類和果蔬的霉腐變質(zhì),該霉菌在原料貯藏期間幾乎不會死亡。因其對干燥抗性強, 故常在一些干燥食品中被分離出來,糖類和殼類處理工廠常被此類霉菌污染,而烘焙產(chǎn)品中也常因原料,如糖、花生、油、大米、大豆、綠豆等原料帶入曲霉菌污染。
曲霉顯微鏡下表現(xiàn):

(1)曲霉菌絲有隔膜,直徑3-6um;
(2)分支呈銳角45°;
(3)菌絲兩側(cè)平行。

肉眼可以通過菌落生長速度,表面質(zhì)地、顏色、形態(tài)和氣味等鑒別,其中顏色是曲霉菌分類的依據(jù)之一 。
(1)煙曲霉
菌落開始為白色,2-3天后轉(zhuǎn)為藍綠色,但邊緣仍為白色,數(shù)日后變?yōu)樯罹G色、煙綠色。初為絨狀或絮狀,隨著時間推移變?yōu)榉勰�,邊緣部分也出現(xiàn)顏色,背面無色或帶點褐色。

(2)黃曲霉
它是溫暖地區(qū)常見曲霉菌,在20-30℃最易產(chǎn)生強致癌的黃曲霉毒素,花生、玉米,大米、小麥、豆類、堅果類、肉類、乳及乳制品、水產(chǎn)品等均有黃曲霉毒素污染。菌落正面色澤也隨其生長由白色變?yōu)辄S色及黃綠色,呈半絨毛狀。孢子成熟后顏色變?yōu)楹稚1砻嫫教够蛴蟹派錉顪霞y,背面無色或略呈褐色。

(3)黑曲霉
黑曲霉菌落初為白色,常有鮮黃色區(qū)域,厚絨狀,繼而黑色,背面無色或中央部分略帶褐色,且能引起曲霉菌病,還能產(chǎn)生黑曲霉毒素。
(4)土曲霉
土曲霉菌落淡褐色或褐色或土黃色,比較小,呈圓形。
(5)雜色曲霉菌
形緊密,呈絨毛狀、羊毛狀或兩者兼有,顏色變化范圍相當(dāng)廣泛,在不同菌株的菌落上,有時局部會出現(xiàn)淡綠、灰綠、淺黃或粉紅等顏色,而菌落背面則近乎無色、黃橙色或玫瑰色;有的菌落上會形成無色至紫紅色的液滴。

(6)構(gòu)巢曲霉菌
菌落圓形,暗綠色,中央呈粉末狀,邊緣絨毛狀,當(dāng)產(chǎn)生大量閉囊殼時呈黃褐色,背面紫紅色。
2、青霉
它是一種常見的污染菌,與曲霉一樣在自然界中廣泛分布,但曲霉生長于中溫至高溫、孢囊梗末端膨大、多為放射狀,而青霉以中溫性為主、孢囊梗末端不膨大、多為掃帚狀,主要藍有灰綠青霉黃綠青霉、桔青霉、島青霉等,從土壤或空氣中很易分離。青霉的孢子耐熱性較強,菌體繁殖溫度較低,酒石酸、蘋果酸、檸檬酸等烘焙產(chǎn)品常用的酸味劑又是它喜愛的碳源,因而常常引起這些制品的霉變,青霉也極易污染稻谷,而使米粒變黃,這類變質(zhì)米稱這為“ 黃變米”。
青霉一般在冬季和春季生長旺盛,容易造成稻谷、水果、蔬菜、肉食及衣履腐敗。若是加強通風(fēng)、降低溫度,減少空氣相對濕度,可以大大減輕青霉的危害。菌落正面有青綠色、藍綠色、黃綠色和灰綠色,四周有明顯的淡色邊緣。

3、毛霉
毛霉又叫黑霉、長毛霉,在土壤、糞便、禾草及空氣等環(huán)境中存在,高溫、高濕度以及通風(fēng)不良的條件下生長良好。在工廠濕度高的環(huán)境、通風(fēng)不良的環(huán)境與氣溫差異顯著的地方(如濕的地板和天花板) , 常有此霉菌存在。
毛霉分為多種毛霉,通常菌落為絮狀,初為白色或灰白色,后變灰至褐灰色,毛霉無假根。毛霉的菌絲多為白色,孢子囊黑色或褐色,孢子囊孢子大部分為無色或淺蘭色,因種而異,主要有以下幾種:
(1)高大毛霉,孢子梗直立不分枝,菌絲不分枝,菌絲高達3-12cm,菌落初為白色,逐漸變?yōu)闇\淡藍色。
(2)總狀毛霉,毛霉中分布中最廣的一種,孢子�?偁罘种�,菌絲灰白,直立稍短。
(3)魯氏毛霉,孢子梗為假軸狀分枝,菌絲在不同的培養(yǎng)基上可略有顏色。

4、根霉
根霉,為腐生菌,最常見的是匍枝根霉【又稱黑根霉、面包霉】和米根霉,多生于面包、饅頭和富含淀粉質(zhì)的食物上,使食物腐爛變質(zhì),又能引起甘薯軟腐病。黑根霉是目前發(fā)酵工業(yè)上常使用的微生物菌種,能糖化淀粉、轉(zhuǎn)化蔗糖 ,產(chǎn)生乳酸、反丁烯二酸及微量酒精。黑根霉需要氧氣才可以存活,最適生長溫度約為28℃,超過32℃不再生長。
無定形菌落,初形成時為灰白色或黃白色,成熟后變成灰褐色或黑色。匍匐菌絲弧形,無色,向四周蔓延。孢子囊剛出現(xiàn)時黃白色,成熟后變成黑色。其中的孢子靠氣流傳播,喜中溫,高溫偏酸的條件。

5、交鏈孢霉
交鏈孢霉屬中溫性和好濕性霉菌,易造成腐朽、腐敗和過敏。在高濕度的工廠環(huán)境(如糕點、魚肉、水產(chǎn)加工與肉食加工環(huán)境) 的天花板、墻與地板、配水管的黑色霉菌, 幾乎為該菌或枝孢霉。菌落呈絨毛狀,多為灰黑色至黑色。
6、鐮刀菌
鐮刀菌是一類世界性分布的真菌,它不僅可以在土壤中越冬越夏,還可侵染多種植物(糧食作物、經(jīng)濟作物、藥用植物及觀賞植物),引起植物的根腐、莖腐、莖基腐、花腐和穗腐等多種病害,寄主植物達100余種。本可產(chǎn)生鐮刀菌毒素,食用霉變的糧食可導(dǎo)致人患病和死亡,某些菌種可誘發(fā)人皮膚和角膜潰瘍,惡性腫瘤的發(fā)生可能與有的菌種有關(guān)。
菌核顏色一般有黃色、白色、紫色、紅色、綠色等。菌核的形狀多為球形,單生或叢生。

三、霉菌的危害
食品受到霉菌污染容易引起食品的變質(zhì),表現(xiàn)為食品表面長出菌絲體,氣味異常,失去食品原有的色香味,導(dǎo)致食品軟化和腐爛,失去食用價值,甚至?xí)a(chǎn)生霉菌毒素。
目前已知的霉菌毒素有200多種,危害比較嚴重的有黃曲霉毒素、赫曲霉毒素、發(fā)色曲霉毒素等。這些毒素可引起人和動物的急、慢性中毒,并與某些癌癥有關(guān),對人體健康和生命安全造成嚴重威脅。但也不是所有的霉菌都是有害的。例如食品發(fā)酵工業(yè)制造腐乳、醬油、豆豉等食品就是應(yīng)用了有益的霉菌,所以不必談“霉”色變。
四、霉菌污染的原因
食品發(fā)生霉變,可能是加工用料受到霉菌污染,或是儲存、運輸控制不當(dāng)引起的。當(dāng)然,只有溫度和濕度等環(huán)境條件適宜時,污染了霉菌的食物才有發(fā)生霉變的可能。大多數(shù)霉菌在濕度為85%~90%、溫度在25℃~30℃范圍內(nèi)會迅速繁殖生長。研究結(jié)果表明,在糧食、豆類、果類及加工制品中,如常用的大米、小米、小麥、黃豆、油料作物的種子、水果、干果、乳制品、發(fā)酵食品和動物飼料中,均發(fā)現(xiàn)過霉菌毒素。同時食品霉菌毒素中毒往往表現(xiàn)明顯的地方性和季節(jié)性,如在南方潮濕的地區(qū)和梅雨季節(jié)比較容易發(fā)生。

五、如何檢測霉菌?
食品中霉菌檢測標準是GB 4789.15-2016《食品安全國家標準 食品微生物學(xué)檢驗霉菌和酵母計數(shù)》,它可以定量測定食品中霉菌數(shù)量,用相應(yīng)的產(chǎn)品標準判定食品中霉菌是否超標。
檢測中的注意事項:
1、 取樣的代表性
2、 取樣工具的無菌
空氣中霉菌的孢子含量很高,所以,取樣的工具、容器等要經(jīng)過嚴格的高壓滅菌。
3、檢樣的方法
(1)由于霉菌易被攜帶,所以,檢樣時操作人員應(yīng)盡量避免自身攜帶的可能。
(2)樣品的均質(zhì)及充分振搖。因為有些孢子是連成串的,故均質(zhì)和振搖能使其充分散開,同時,在各梯度連續(xù)稀釋時,也要用滅菌吸管反復(fù)吹吸幾次,使孢子充分散開。
4、培養(yǎng)溫度和時間
培養(yǎng)溫度 25-28℃培養(yǎng),5 天后觀察。
霉菌檢驗中常用的培養(yǎng)基:孟加拉紅瓊脂、馬鈴薯葡萄糖瓊脂、察氏瓊脂、高鹽察氏瓊脂等。
5、檢樣中常見的問題
(1)不同稀釋度計數(shù)結(jié)果不相同;
(2)不生長或生長很好連成片無法計數(shù);
原因:①稀釋時未經(jīng)反復(fù)振搖,吹吸,導(dǎo)致孢子未充分散開,影響了計數(shù)的結(jié)果。②由于培養(yǎng)基不適宜,PH 值低等,致使生長較慢。③觀察時間的掌握。真菌生長較慢,故需 5d 后才能觀察出結(jié)果。
微生物操作中常見問題的討論與分析:
1、 劃線獲得單個菌落的方法
劃不出單個菌落的原因:
(1)平板上有過多的水分;
(2)劃線時接種環(huán)未經(jīng)反復(fù)灼燒;
(3)多區(qū)劃線,三區(qū)或四區(qū)劃線。
2、 涂布和傾注的區(qū)別:
涂布利于觀察,但由于涂布棒上會帶有少量的菌液,可能影響計數(shù)的準確性;傾注更為準確,但不利于觀察菌落的狀態(tài)。
Beuchat和Matsuda等人分別對這兩種方法作了大量比較試驗后發(fā)現(xiàn),對霉菌計數(shù)來說,涂抹法有以下幾方面優(yōu)越于傾注法:①培養(yǎng)出的霉菌菌落數(shù)較多;②培養(yǎng)所需的時間較短;③霉菌孢子、菌落形態(tài)特征發(fā)育完全,便于鑒定。這是因為絕大多數(shù)霉菌是好氧的,在培養(yǎng)基表面生長快,發(fā)育好,而混在培養(yǎng)基中發(fā)育就受影響,而且在培養(yǎng)基傾注時霉菌孢子易受熱損傷。
3、培養(yǎng)基的選擇
培養(yǎng)基的選擇應(yīng)根據(jù)實驗材料和檢驗?zāi)康膩泶_定。目前國標方法中使用的培養(yǎng)基有:馬鈴薯葡萄糖瓊脂(PDA)、孟加拉培養(yǎng)基(RBC)、高鹽察氏培養(yǎng)基(CAO),其中PDA和RBC適合于一般的霉菌和酵母菌生長,而CAO則適合于高滲性霉菌生長,酵母菌幾乎不長。
在日常檢測中我們發(fā)現(xiàn),有些常見的耐高滲性霉菌,如局限曲霉、謝瓦曲霉、赤曲霉、Wallemia等在PDA、RBC上生長非常緩慢或不長,而這些菌在高滲培養(yǎng)基如M40Y、DG18(M40Y瓊脂配方:蔗糖400g,麥芽提取汁20g,酵母提取汁5g,瓊脂20g,氯霉素50mg,蒸餾水1000mL;DG18瓊脂配方:葡萄糖10g,蛋白胨5g,KH2PO41g,MgSO4·7H2O 0.5g,氯霉素0.1g,0.2%二氯硝基苯胺1.0mL,瓊脂15g,蒸餾水1000mL,PH6.5)上則正常生長。孢子、形態(tài)特征發(fā)育良好,而且酵母菌也能在M40Y、DG18上生長,因此,若能同時采用PDA和M40Y(或DG18)分離培養(yǎng)各類樣品中的霉菌,將能更全面地反映出污染霉菌的菌相。特別是對干燥食品、高糖食品、淹漬食品等,更有必要同時采用M40Y或DG18。
由于霉菌中很多種類不會產(chǎn)生有毒的霉菌毒素,危害較小,而有的菌株即使污染數(shù)量不多,但其產(chǎn)生的霉菌毒素卻危害較大,因此僅作霉菌計數(shù)并不能全面反映其危害程度,重要的是要知道污染菌的菌相,才能更好地判斷被污染食品的安全程度。
為此,國外有些研究者設(shè)計出各類選擇性培養(yǎng)基,可以識別產(chǎn)毒的霉菌。如AFPA培養(yǎng)基(配方:酵母提取汁20g,蛋白胨10g,檸檬酸鐵銨0.5g,0.2%二氯硝基苯胺1.0mL,瓊脂15g,蒸餾水1000mL,PH5.6)用于分離黃曲霉毒素產(chǎn)生菌高污染率的食品。產(chǎn)黃曲霉毒素的菌株黃曲霉和寄生曲霉在AFPA上30℃培養(yǎng)2~3天就形成背面有亮橙黃色的特征性菌落,非常容易識別。有人利用該培養(yǎng)基分離黃曲霉高污染食品花生、玉米等,取得了滿意的結(jié)果。因此,針對不同樣品,有目的地設(shè)計出相應(yīng)的選擇性培養(yǎng)基,以篩選污染菌中的危險菌群,將是一個值得探索的方向。
4、 培養(yǎng)基配制時應(yīng)注意的問題:
(1)滅菌溫度要嚴格控制,按照要求滅菌,尤其含糖量較高的培養(yǎng)基溫度不應(yīng)太高,過高會導(dǎo)致糖分焦化,影響質(zhì)量;
(2)瓊脂培養(yǎng)基不能反復(fù)溶化。反復(fù)溶化會破壞培養(yǎng)基中的營養(yǎng)成分;
(3)培養(yǎng)基不能反復(fù)滅菌,反復(fù)滅菌也會導(dǎo)致營養(yǎng)成分的破壞;
(4)含瓊脂的培養(yǎng)基滅菌后,要搖勻。
5、平板的保存:
大多數(shù)平板如 VRBA、DC、尿素酶生化管、顯色系列等要避光低溫保存。
6、 產(chǎn)品的保存:
(1)干粉培養(yǎng)基:避光干燥,結(jié)塊后不能使用。
(2)亞碲酸鉀卵黃增菌液、50%卵黃乳液等:冷凍保存,使用時,要常溫解凍,避免水浴加熱。
(3)抗生素類:冷藏保存,溫度過高會導(dǎo)致靈敏度的下降。
(4)兔血漿:冷藏保存少量的紅色不會影響結(jié)果。
7、 觀察時間的掌握:
按SN、GB 等標準或培養(yǎng)基的使用說明所述時間進行觀察,時間過短或時間過長,單菌落的特征都不會很明顯。如單增李斯特氏菌顯色培養(yǎng)基,時間短單菌落看不到卵磷脂環(huán),時間長綿羊李氏菌也會產(chǎn)生沉淀環(huán)。OXA、PALCAM的觀察也如此,時間過長,李氏菌使整個平板成黑色,不利于觀察單個菌落。
8、 添加劑的添加:
(1)溫度的掌握。卵黃和抗生素類添加的溫度都不應(yīng)太高。
(2)定量。過多會抑制一些目標菌,太少又導(dǎo)致雜菌的過度生長。
9、 培養(yǎng)溫度的掌握:
(1)真菌類。25-28℃培養(yǎng)
(2)細菌類。李氏菌在增菌和生化中要求培養(yǎng)溫度在 30℃左右。
(3)其他一般在 36℃左右。
10、接種方法:
常用的方法主要有劃線、三點接種、穿刺接種、傾注接種、涂布接種、液體接種。
11、革蘭氏染色方法:
染色時間的掌握、沖洗的方法。
12、生化實驗:
(1)接種的方法
(2)氧化型和發(fā)酵型實驗操作
(3)陽性菌種的對照
(4)接種前的純化。挑取單個菌落進行一系列的生化。
13、最適計數(shù)范圍
霉菌菌落由孢子和菌絲組成,相當(dāng)擴散,在直徑9cm的平皿里,菌落數(shù)稍多就相互交叉重疊,影響計數(shù),但數(shù)量太少又會產(chǎn)生較大的誤差,因此選擇適當(dāng)?shù)南♂尪扔嫈?shù)是保證結(jié)果準確的關(guān)鍵環(huán)節(jié)之一。
我們對這方面作了一些觀察研究,首先是將實驗菌株的斜面培養(yǎng)物制成含有約106個/mL的孢子懸液,并用血球計數(shù)器在顯微鏡下準確計數(shù),然后將孢子懸液作10-1~10-6倍稀釋,吸取不同稀釋度的稀釋液接種于PDA,25℃培養(yǎng)5天后計數(shù)。30種常見霉菌的兩種不同計數(shù)方法所得結(jié)果比較顯示,大部分菌株每平板含有10~50個菌落的稀釋度時的計數(shù)與顯微鏡計數(shù)結(jié)果最接近;有近一半的菌株,每個平板含50~100個菌落已較難計數(shù),而大部分菌株,超過100個/平皿或小于10個/平皿的計數(shù)結(jié)果就與顯微計數(shù)結(jié)果存在較大差別,因此,應(yīng)盡量選擇10~50個/平皿的稀釋度進行霉菌計數(shù)。
而對上述提及的菌絲很豐富、菌落特別擴散的毛霉、根霉、犁頭霉等菌株,則應(yīng)在更少的范圍內(nèi)計數(shù)(30個/平皿以內(nèi))。為控制霉菌的生長速度和菌落的生長范圍,可在培養(yǎng)基中添加少量抗生素,如氯霉素(50~100mg/L),金霉素(20~100mg/L),慶大霉素(50mg/L),土霉素(100mg/L)等。
14、關(guān)于殺菌的幾個概念:
(1)抑制:是在亞抑制劑量因子作用下導(dǎo)致微生物生長停止,但在移去這些因子后生長仍可以恢復(fù)的生物學(xué)現(xiàn)象。
(2)死亡:在致死劑量因子的作用下或在亞致死劑量因子長時間的作用下,導(dǎo)致微生物生長能力不可逆喪失,即使移去這種因子后生長仍不能恢復(fù)的生物學(xué)現(xiàn)象。
(3)防腐:在某些化學(xué)物質(zhì)或物理因子作用下,能防止或抑制微生物生長的一種措施,它能防止食物腐敗或防止食物霉變。
(4)消毒:利用某種方法殺死或滅活物質(zhì)或物體中所有病原微生物的一種措施,它可以起到防止感染和傳播的作用。
(5)滅菌:利用某種方法殺死物體中包括芽孢在內(nèi)的所有病原微生物的一種措施。
六、如何預(yù)防霉菌污染?
那么有什么預(yù)防霉菌污染的措施呢?
控制食品中的水分和食品儲存環(huán)境中的溫度、濕度是防霉的主要措施。食物的水分要控制在安全水分以下,如玉米在12.5%以下、花生仁在8.0%以下時,霉菌不易繁殖。

另外食品儲藏的場所要具有良好的通風(fēng)條件,且要防水和防雨。食品儲存要注意推陳出新,合理儲量,儲存的時間不宜過長等。同時為了避免食品受霉菌的污染,打開食品包裝后應(yīng)當(dāng)及時密封。有條件的可以定期對食品進行檢測,一旦發(fā)現(xiàn)食品遇到霉菌污染后,及時將受到污染的食品進行分析處理,可大大降低霉菌的污染。








當(dāng)前所在頁面:















